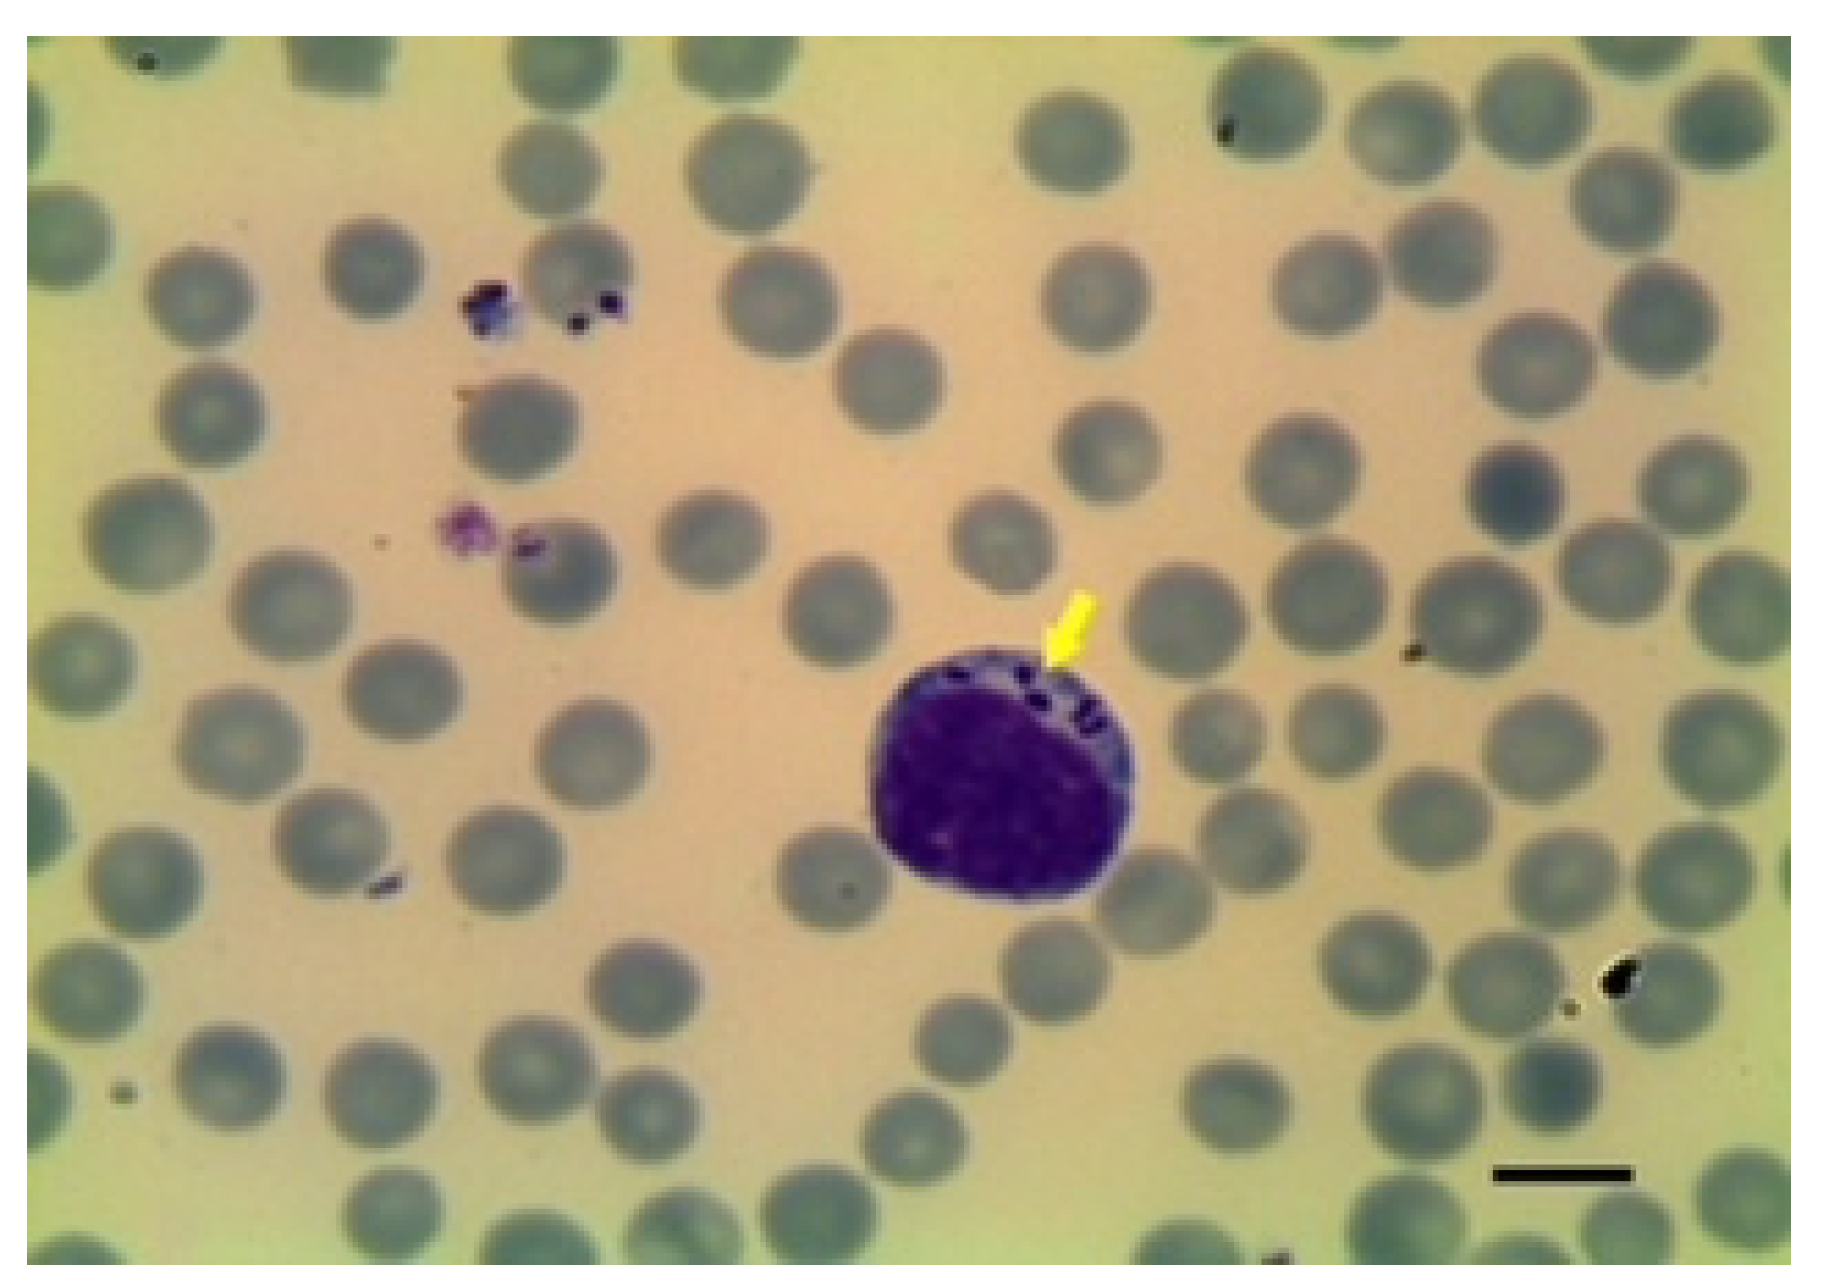

Anaemia in Sheep Caused by Babesia and Theileria Haemoparasites
Abstract
Simple Summary
Abstract
1. Introduction
2. Babesia
2.1. Epidemiology and Transmission
2.2. Pathogenesis
2.3. Clinicopathological Findings
2.4. Diagnosis
3. Theileria
3.1. Epidemiology and Transmission
3.2. Pathogenesis
3.3. Clinicopathological Findings
3.4. Diagnosis
4. Conclusions
Author Contributions
Funding
Institutional Review Board Statement
Informed Consent Statement
Data Availability Statement
Conflicts of Interest
References
- Stuen, S. Haemoparasitism of Goats and Sheep. In Sustainable Goat Production in Adverse Environments: Volume I; Simões, J., Gutiérrez, C., Eds.; Springer: Cham, Switzerland, 2017. [Google Scholar] [CrossRef]
- Faburay, B. The case for a ‘one health’ approach to combating vector-borne diseases. Infect. Ecol. Epidemiol. 2015, 5, 28132. [Google Scholar] [CrossRef]
- Tabor, A.; Graves, S.; Valle, M.R.; Stenos, J. ‘One Health’ solutions for ticks and tick-borne diseases, and rickettsial pathogens of humans, domestic animals and wildlife. Ticks Tick-Borne Dis. 2018, 9, 1604–1605. [Google Scholar] [CrossRef] [PubMed]
- Halabi, S.F. Adaptation of Animal and Human Health Surveillance Systems for Vector-Borne Diseases Accompanying Climate Change. J. Law Med. Ethic. 2020, 48, 694–704. [Google Scholar] [CrossRef]
- Onyiche, T.E.; Suganuma, K.; Igarashi, I.; Yokoyama, N.; Xuan, X.; Thekisoe, O. A Review on Equine Piroplasmosis: Epidemiology, Vector Ecology, Risk Factors, Host Immunity, Diagnosis and Control. Int. J. Environ. Res. Public Health 2019, 16, 1736. [Google Scholar] [CrossRef] [PubMed]
- Almazán, C.; Scimeca, R.C.; Reichard, M.V.; Mosqueda, J. Babesiosis and Theileriosis in North America. Pathogens 2022, 11, 168. [Google Scholar] [CrossRef]
- Caracappa, S. Livestock production and animal health in Sicily, Italy. Parassitologia 1999, 41 (Suppl. 1), 17–23. [Google Scholar] [PubMed]
- De Castro, J.; Young, A.; Dransfield, R.; Cunningham, M.; Dolan, T. Effects of tick infestation on Boran (Bos indicus) cattle immunised against theileriosis in an endemic area of Kenya. Res. Vet.-Sci. 1985, 39, 279–288. [Google Scholar] [CrossRef]
- Sevinc, F.; Turgut, K.; Sevinc, M.; Ekici, O.D.; Coskun, A.; Koc, Y.; Erol, M.; Ica, A. Therapeutic and prophylactic efficacy of imidocarb dipropionate on experimental Babesia ovis infection of lambs. Vet. Parasitol. 2007, 149, 65–71. [Google Scholar] [CrossRef]
- Savini, G.; Conte, A.; Semproni, G.; Scaramozzino, P. Tick-borne diseases in ruminants of Central and Southern Italy: Epidemiology and case reports. Parassitologia 1999, 41 (Suppl. 1), 95–100. [Google Scholar]
- Katsogiannou, E.G.; Athanasiou, L.V.; Christodoulopoulos, G.; Polizopoulou, Z.S. Diagnostic approach of anemia in ruminants. J. Hell. Vet.-Med. Soc. 2018, 69, 1033–1046. [Google Scholar] [CrossRef]
- Cornell University College of Veterinary Medicine (ECLINPATH). Available online: https://eclinpath.com/chemistry/techniques/basic-rgb-4/ (accessed on 15 July 2022).
- Babes, V. Sur l’hémoglobinurie bactérienne du boeuf. CR Acad. Sci. 1888, 107, 692–694. [Google Scholar]
- Babes, V. L’etiologie d’une enzootie des moutons, dénommé Carceag en Roumanie. CR Hebd. Acad. Sci. 1892, 115, 359–361. [Google Scholar]
- Starcovici, C. Bemerkungen u¨ber den durch Babes entdeckten Blutparasiten und die durch denselben hervorgebrachten Krakheiten, die seuchenhafte Ha¨moglobinurie des Rindes (Babes), dans Texasfieber (Th. Smith) und der Carceag der Schafe (Babes). Zbl. Bakt. I. Abt. 1893, 14, 1–8. [Google Scholar]
- Schnittger, L.; Rodriguez, A.E.; Florin-Christensen, M.; Morrison, D.A. Babesia: A world emerging. Infect. Genet. Evol. 2012, 12, 1788–1809. [Google Scholar] [CrossRef] [PubMed]
- Ganzinelli, S.; Rodriguez, A.; Schnittger, L.; Florin-Christensen, M. Babesia in Domestic Ruminants. In Parasitic Protozoa of Farm Animals and Pets; Florin-Christensen, M., Schnittger, L., Eds.; Springer: Cham, Switzerland, 2018. [Google Scholar] [CrossRef]
- Hunfeld, K.-P.; Hildebrandt, A.; Gray, J.S. Babesiosis: Recent insights into an ancient disease. Int. J. Parasitol. 2008, 38, 1219–1237. [Google Scholar] [CrossRef]
- Friedhoff, K.T. Tick-borne diseases of sheep and goats caused by Babesia, Theileria or Anaplasma spp. Parassitologia 1997, 39, 99–109. [Google Scholar]
- Ahmed, J.S.; Schnittger, L.; Yin, H.; Gubbels, M.-J.; Beyer, D.; Jongejan, F.; Niemann, S. Phylogeny of sheep and goat Theileria and Babesia parasites. Parasitol. Res. 2003, 91, 398–406. [Google Scholar] [CrossRef] [PubMed]
- Hornok, S.; Takács, N.; Kontschán, J.; György, Z.; Micsutka, A.; Iceton, S.; Flaisz, B.; Farkas, R.; Hofmann-Lehmann, R. Diversity of Haemaphysalis-associated piroplasms of ruminants in Central-Eastern Europe, Hungary. Parasites Vectors 2015, 8, 627. [Google Scholar] [CrossRef] [PubMed]
- Kumar, B.; Manjunathachar, H.V.; Ghosh, S. A review on Hyalomma species infestations on human and animals and progress on management strategies. Heliyon 2020, 6, e05675. [Google Scholar] [CrossRef] [PubMed]
- Stuen, S. Haemoparasites—Challenging and Wasting Infections in Small Ruminants: A Review. Animals 2020, 10, 2179. [Google Scholar] [CrossRef] [PubMed]
- Ranjbar-Bahadori, S.; Eckert, B.; Omidian, Z.; Shirazi, N.S.; Shayan, P. Babesia ovis as the main causative agent of sheep babesiosis in Iran. Parasitol. Res. 2011, 110, 1531–1536. [Google Scholar] [CrossRef] [PubMed]
- Mira, A.; Unlu, A.H.; Bilgic, H.B.; Bakirci, S.; Hacilarlioglu, S.; Karagenc, T.; Carletti, T.; Weir, W.; Shiels, B.; Shkap, V.; et al. High genetic diversity and differentiation of the Babesia ovis population in Turkey. Transbound. Emerg. Dis. 2019, 67 (Suppl. 2), 26–35. [Google Scholar] [CrossRef]
- Habibi, G.; Sepahvand-Mohammadi, E.; Afshari, A.; Bozorgi, S. Molecular detection of Theileria spp. and Babesia ovis infection in sheep in Baneh County, Kurdistan Province of Iran. Arch. Razi Inst. 2020, 75, 289–296. [Google Scholar] [CrossRef] [PubMed]
- Wang, J.M.; Ma, M.L.; Liu, A.H.; Ren, Q.Y.; Li, A.Y.; Liu, Z.J.; Li, Y.Q.; Yin, H.; Luo, J.X.; Guan, G.Q. A sero-epidemiological survey of Chinese Babesia motasi for small ruminants in China. Parasitol. Res. 2013, 112, 2387–2391. [Google Scholar] [CrossRef] [PubMed]
- Liu, A.; Yin, H.; Guan, G.; Schnittger, L.; Liu, Z.; Ma, M.; Dang, Z.; Liu, J.; Ren, Q.; Bai, Q.; et al. At least two genetically distinct large Babesia species infective to sheep and goats in China. Vet. Parasitol. 2007, 147, 246–251. [Google Scholar] [CrossRef] [PubMed]
- Niu, Q.; Liu, Z.; Yang, J.; Yu, P.; Pan, Y.; Zhai, B.; Luo, J.; Moreau, E.; Guan, G.; Yin, H. Expression analysis and biological characterization of Babesia sp. BQ1 (Lintan) (Babesia motasi-like) rhoptry-associated protein 1 and its potential use in serodiagnosis via ELISA. Parasites Vectors 2016, 9, 313. [Google Scholar] [CrossRef] [PubMed]
- Niu, Q.; Liu, Z.; Yang, J.; Gao, S.; Pan, Y.; Guan, G.; Luo, J.; Yin, H. Genetic characterization and molecular survey of Babesia sp. Xinjiang infection in small ruminants and ixodid ticks in China. Infect. Genet. Evol. 2017, 49, 330–335. [Google Scholar] [CrossRef]
- Giadinis, N.D.; Chochlakis, D.; Dvm, M.K.-K.; Makridaki, E.; Tselentis, Y.; Kostopoulou, D.; Karatzias, H.; Psaroulaki, A.; Dvm, N.D.G.; Bsc, M.D.C.; et al. Haemolytic disease in sheep attributed to a Babesia lengau -like organism. Vet. Rec. 2012, 170, 155. [Google Scholar] [CrossRef]
- Saviä, S.; Vidiä, B.; Grgiä, Z.; Potkonjak, A.; Spasojevic, L. Emerging Vector-Borne Diseases – Incidence through Vectors. Front. Public Health 2014, 2, 267. [Google Scholar] [CrossRef] [PubMed]
- Jia, N.; Zheng, Y.-C.; Jiang, J.-F.; Jiang, R.-R.; Jiang, B.-G.; Wei, R.; Liu, H.-B.; Huo, Q.-B.; Sun, Y.; Chu, Y.-L.; et al. Human Babesiosis Caused by a Babesia crassa–Like Pathogen: A Case Series. Clin. Infect. Dis. 2018, 67, 1110–1119. [Google Scholar] [CrossRef]
- Elsify, A.; Sivakumar, T.; Nayel, M.; Salama, A.; Elkhtam, A.; Rizk, M.; Mosaab, O.; Sultan, K.; Elsayed, S.; Igarashi, I.; et al. An epidemiological survey of bovine Babesia and Theileria parasites in cattle, buffaloes, and sheep in Egypt. Parasitol. Int. 2015, 64, 79–85. [Google Scholar] [CrossRef] [PubMed]
- Mahmoud, M.S.; Kandil, O.M.; Nasr, S.M.; Hendawy, S.H.; Habeeb, S.M.; Mabrouk, D.M.; Silva, M.G.; Suarez, C.E. Serological and molecular diagnostic surveys combined with examining hematological profiles suggests increased levels of infection and hematological response of cattle to babesiosis infections compared to native buffaloes in Egypt. Parasites Vectors 2015, 8, 319. [Google Scholar] [CrossRef] [PubMed]
- Solano-Gallego, L.; Sainz, Á.; Roura, X.; Peña, A.E.; Miró, G. A review of canine babesiosis: The European perspective. Parasites Vectors 2016, 9, 336. [Google Scholar] [CrossRef] [PubMed]
- Wozniak, E.J.; Barr, B.C.; Thomford, J.W.; Yamane, I.; McDonough, S.P.; Moore, P.F.; Naydan, D.; Robinson, T.W.; Conrad, P.A. Clinical, anatomic, and immunopathologic characterisation of Babesia gibsoni infection in the domestic dog (Canis familiaris). J. Parasitol. 1997, 83, 692–699. [Google Scholar] [CrossRef] [PubMed]
- Moreau, E.; Jouglin, M.; Chauvin, A.; Malandrin, L. Babesia divergens experimental infection of spleen-intact sheep results in long-lasting parasitemia despite a strong humoral response: Preliminary results. Vet. Parasitol. 2009, 166, 205–211. [Google Scholar] [CrossRef]
- Henning, A.; Clift, S.J.; Leisewitz, A.L. The pathology of the spleen in lethal canine babesiosis caused by Babesia rossi. Parasite Immunol. 2020, 42, e12706. [Google Scholar] [CrossRef]
- Vercammen, F.; De Deken, R.; Maes, L. Clinical and serological observations on experimental infections with Babesia canis and its diagnosis using the IFAT. Parasite 1995, 2, 407–410. [Google Scholar] [PubMed]
- Yeruham, I.; Hadani, A.; Galker, F.; Avidar, Y.; Bogin, E. Clinical, Clinico-Pathological and Serological Studies of Babesia ovis in Experimentally Infected Sheep. J. Vet.-Med. Ser. B 1998, 45, 385–394. [Google Scholar] [CrossRef] [PubMed]
- Narurkar, R.; Mamorska-Dyga, A.; Nelson, J.C.; Liu, D. Autoimmune hemolytic anemia associated with babesiosis. Biomark. Res. 2017, 5, 14. [Google Scholar] [CrossRef] [PubMed]
- Garden, O.A.; Kidd, L.; Mexas, A.M.; Chang, Y.-M.; Jeffery, U.; Blois, S.L.; Fogle, J.E.; MacNeill, A.L.; Lubas, G.; Birkenheuer, A.; et al. ACVIM consensus statement on the diagnosis of immune-mediated hemolytic anemia in dogs and cats. J. Vet.-Intern. Med. 2018, 33, 313–334. [Google Scholar] [CrossRef]
- Bai, Q.; Liu, G.; Liu, D.; Ren, J.; Li, X. Isolation and preliminary characterization of a large Babesia sp. from sheep and goats in the eastern part of Gansu Province, China. Parasitol. Res. 2002, 88, S16–S21. [Google Scholar] [CrossRef] [PubMed]
- Sevinc, F.; Sevinc, M.; Ekici, O.D.; Yildiz, R.; Isik, N.; Aydogdu, U. Babesia ovis infections: Detailed clinical and laboratory observations in the pre-and post-treatment periods of 97 field cases. Vet. Parasitol. 2013, 191, 35–43. [Google Scholar] [CrossRef]
- Uilenberg, G. Babesia—A historical overview. Vet. Parasitol. 2006, 138, 3–10. [Google Scholar] [CrossRef] [PubMed]
- Habela, M.; Reina, D.; Nieto, C.; Navarrete, I. Antibody response and duration of latent infection in sheep following experimental infection with Babesia ovis. Vet. Parasitol. 1990, 35, 1–10. [Google Scholar] [CrossRef] [PubMed]
- Alessandra, T.; Santo, C. Tick-borne diseases in sheep and goats: Clinical and diagnostic aspects. Small Rumin. Res. 2012, 106, S6–S11. [Google Scholar] [CrossRef]
- Yeruham, I.; Hadani, A.; Galker, F. Some epizootiological and clinical aspects of ovine babesiosis caused by Babesia ovis—A review. Vet. Parasitol. 1998, 74, 153–163. [Google Scholar] [CrossRef]
- Alani, A.; Herbert, I. Pathogenesis of infection with Theileria recondita (Wales) isolated from Haemaphysalis punctata from North Wales. Vet. Parasitol. 1988, 28, 293–301. [Google Scholar] [CrossRef]
- Rahbari, S.; Nabian, S.; Khaki, Z.; Alidadi, N.; Ashrafihelan, J. Clinical, haematologic and pathologic aspects of experi-mental ovine babesiosis in Iran. Iran. J. Vet. Res. 2008, 9, 59–64. [Google Scholar]
- Horta, S.; Barreto, M.C.; Pepe, A.; Campos, J.; Oliva, A. Highly sensitive method for diagnosis of subclinical B. ovis infection. Ticks Tick-Borne Dis. 2014, 5, 902–906. [Google Scholar] [CrossRef]
- Malandrin, L.; Jouglin, M.; Moreau, E.; Chauvin, A. Individual heterogeneity in erythrocyte susceptibility to Babesia divergens is a critical factor for the outcome of experimental spleen-intact sheep infections. Vet. Res. 2009, 40, 25. [Google Scholar] [CrossRef] [PubMed]
- Pieragostini, E.; Ciani, E.; Rubino, G.; Petazzi, F. Tolerance to tick-borne diseases in sheep: Highlights of a twenty-year experience in a Mediterranean environment. In Health Management–Different Approaches and Solutions; BoD–Books on Demand: Norderstedt, Germany, 2011. [Google Scholar]
- Cray, C. Protein electrophoresis of non-traditional species: A review. Vet.-Clin. Pathol. 2021, 50, 478–494. [Google Scholar] [CrossRef] [PubMed]
- Moore, A.R.; Avery, P.R. Protein characterization using electrophoresis and immunofixation; a case-based review of dogs and cats. Vet.-Clin. Pathol. 2019, 48, 29–44. [Google Scholar] [CrossRef] [PubMed]
- Esmaeilnejad, B.; Tavassoli, M.; Asri-Rezaei, S.; Dalir-Naghadeh, B.; Mardani, K.; Farhaghpajouh, F.; Abtahi, S.M. Serum protein alterations in goats naturally infected with Babesia ovis. Iran. J. Vet. Res. 2013, 14, 150–154. [Google Scholar]
- Apaydin, B.; Dede, S. Electrophoretic profile of serum protein fractions from sheep naturally infected with Babesia ovis. Rev. Méd. Vét. 2010, 161, 57–60. [Google Scholar]
- Kage, S.; Mamatha, G.S.; Lakkundi, J.N.; Shivashankar, B.P.; D’Souza, P.E. Detection of incidence of Babesia spp. in sheep and goats by parasitological diagnostic techniques. J. Parasit. Dis. 2019, 43, 452–457. [Google Scholar] [CrossRef] [PubMed]
- Gray, A.; Capewell, P.; Loney, C.; Katzer, F.; Shiels, B.R.; Weir, W. Sheep as Host Species for Zoonotic Babesia venatorum, United Kingdom. Emerg. Infect. Dis. 2019, 25, 2257–2260. [Google Scholar] [CrossRef]
- Kumar, A.; O’Bryan, J.; Krause, P.J. The Global Emergence of Human Babesiosis. Pathogens 2021, 10, 1447. [Google Scholar] [CrossRef] [PubMed]
- Ceylan, O.; Sevinc, F. Endemic instability of ovine babesiosis in Turkey: A country-wide sero-epidemiological study. Vet. Parasitol. 2020, 278, 109034. [Google Scholar] [CrossRef]
- Duzgun, A.; Wright, I.; Waltisbuhl, D.; Gale, K.; Goodger, B.; Dargie, J.; Alabay, M.; Cerci, H. An ELISA for the diagnosis of Babesia ovis infection utilizing a synthetic, Babesia bovis-derived antigen. Vet. Parasitol. 1991, 39, 225–231. [Google Scholar] [CrossRef]
- Alvarez, J.A.; Rojas, C.; Figueroa, J.V. Diagnostic Tools for the Identification of Babesia sp. in Persistently Infected Cattle. Pathogens 2019, 8, 143. [Google Scholar] [CrossRef]
- Theodoropoulos, G.; Gazouli, M.; Ikonomopoulos, J.; Kantzoura, V.; Kominakis, A. Determination of prevalence and risk factors of infection with Babesia in small ruminants from Greece by polymerase chain reaction amplification. Vet. Parasitol. 2006, 135, 99–104. [Google Scholar] [CrossRef] [PubMed]
- Guan, G.; Chauvin, A.; Luo, J.; Inoue, N.; Moreau, E.; Liu, Z.; Gao, J.; Thekisoe, O.M.; Ma, M.; Liu, A.; et al. The development and evaluation of a loop-mediated isothermal amplification (LAMP) method for detection of Babesia spp. infective to sheep and goats in China. Exp. Parasitol. 2008, 120, 39–44. [Google Scholar] [CrossRef] [PubMed]
- Niu, Q.; Luo, J.; Guan, G.; Ma, M.; Liu, Z.; Liu, A.; Dang, Z.; Gao, J.; Ren, Q.; Li, Y.; et al. Detection and differentiation of ovine Theileria and Babesia by reverse line blotting in China. Parasitol. Res. 2009, 104, 1417–1423. [Google Scholar] [CrossRef] [PubMed]
- Erster, O.; Roth, A.; Wolkomirsky, R.; Leibovich, B.; Savitzky, I.; Zamir, S.; Molad, T.; Shkap, V. Molecular detection of Babesia ovis in sheep and ticks using the gene encoding B. ovis surface protein D (BoSPD). Vet. Parasitol. 2015, 214, 282–288. [Google Scholar] [CrossRef] [PubMed]
- Nagore, D.; García-Sanmartín, J.; García-Pérez, A.L.; Juste, R.A.; Hurtado, A. Identification, genetic diversity and prevalence of Theileria and Babesia species in a sheep population from Northern Spain. Int. J. Parasitol. 2004, 34, 1059–1067. [Google Scholar] [CrossRef]
- Ahmed, J.S.; Luo, J.; Schnittger, L.; Seitzer, U.; Jongejan, F.; Yin, H. Phylogenetic Position of Small-Ruminant Infecting Piroplasms. Ann. N. Y. Acad. Sci. 2006, 1081, 498–504. [Google Scholar] [CrossRef]
- Bami, M.H.; Haddadzadeh, H.; Kazemi, B.; Khazraiinia, P.; Bandehpour, M.; Aktas, M. Molecular identification of ovine Theileria species by a new PCR–RFLP method. Vet. Parasitol. 2009, 161, 171–177. [Google Scholar] [CrossRef]
- Stuen, S. Haemoparasites in small ruminants in European countries: Challenges and clinical relevance. Small Rumin. Res. 2016, 142, 22–27. [Google Scholar] [CrossRef]
- Schnittger, L.; Yin, H.; Jianxun, L.; Ludwig, W.; Shayan, P.; Rahbari, S.; Voss-Holtmann, A.; Ahmed, J.S. Ribosomal small-subunit RNA gene-sequence analysis of Theileria lestoquardi and a Theileria species highly pathogenic for small ruminants in China. Parasitol. Res. 2000, 86, 352–358. [Google Scholar] [CrossRef]
- Altay, K.; Dumanli, N.; Aktas, M. Molecular identification, genetic diversity and distribution of Theileria and Babesia species infecting small ruminants. Vet. Parasitol. 2007, 147, 161–165. [Google Scholar] [CrossRef]
- Tian, Z.; Liu, G.; Yin, H.; Xie, J.; Wang, S.; Yuan, X.; Wang, F.; Luo, J. First report on the occurrence of Theileria sp. OT3 in China. Parasitol. Int. 2014, 63, 403–407. [Google Scholar] [CrossRef]
- Zakian, A.; Nouri, M.; Barati, F.; Kahroba, H.; Jolodar, A.; Rashidi, F. Vertical transmission of Theileria lestoquardi in sheep. Vet. Parasitol. 2014, 203, 322–325. [Google Scholar] [CrossRef] [PubMed]
- Al-Hamidhi, S.; Elshafie, E.I.; Yaghfoori, S.; Morrison, W.I.; Johnson, E.H.; Babiker, H.A. A comparative study of single Theileria lestoquardi and mixed infections with Theileria ovis. Parasites Vectors 2021, 14, 370. [Google Scholar] [CrossRef]
- Panel, E.; Ahaw, W. Scientific Opinion on Geographic Distribution of Tick-borne Infections and their Vectors in Europe and the other Regions of the Mediterranean Basin. EFSA J. 2010, 8, 1723. [Google Scholar] [CrossRef]
- Yin, H.; Luo, J.; Schnittger, L.; Guan, G.; Bai, Q.; Lu, C.; Ahmed, J.; Lu, B.; Beyer, D.; Ma, M. Phylogenetic analysis of Theileria species transmitted by Haemaphysalis qinghaiensis. Parasitol Res. 2003, 92, 36–42. [Google Scholar] [CrossRef]
- Phipps, L.P.; Hernández-Triana, L.M.; Goharriz, H.; Welchman, D.; Johnson, N. Detection of Theileria luwenshuni in sheep from Great Britain. Parasites Vectors 2016, 9, 203. [Google Scholar] [CrossRef] [PubMed]
- Yin, H.; Schnittger, L.; Luo, J.; Seitzer, U.; Ahmed, J.S. Ovine theileriosis in China: A new look at an old story. Parasitol Res. 2007, 101 (Suppl. 2), S191–S195. [Google Scholar] [CrossRef] [PubMed]
- Mans, B.J.; Pienaar, R.; Latif, A.A. A review of Theileria diagnostics and epidemiology. Int. J. Parasitol. Parasites Wildl. 2015, 4, 104–118. [Google Scholar] [CrossRef]
- El Imam, A.H.; Hassan, S.M.; Gameel, A.A.; El Hussein, A.M.; Taha, K.M.; Salih, D.A. Variation in susceptibility of three Sudanese sheep ecotypes to natural infection with Theileria lestoquardi. Small Rumin. Res. 2015, 124, 105–111. [Google Scholar] [CrossRef]
- Tageldin, M.H.; Fadiya, A.A.-K.; Sabra, A.A.-Y.; Ismaily, S.I.A.-I. Theileriosis in sheep and goats in the Sultanate of Oman. Trop. Anim. Health Prod. 2005, 37, 491–493. [Google Scholar] [CrossRef]
- Naz, S.; Maqbool, A.; Ahmed, S.; Ashraf, K.; Ahmed, N.; Saeed, K.; Latif, M.; Iqbal, J.; Ali, Z.; Shafi, K.; et al. Preva-lence of Theileriosis in Small Ruminants in Lahore-Pakistan. J. Vet Anim. Sci. 2012, 2, 16–20. [Google Scholar]
- Hassan, M.A.; Raoofi, A.; Lotfollahzadeh, S.; Javanbakht, J. Clinical and cytological characteristics and prognostic implications on sheep and goat Theileria infection in north of Iran. J. Parasit. Dis. 2013, 39, 190–193. [Google Scholar] [CrossRef] [PubMed]
- El Imam, A.H.; Taha, K.M. Malignant ovine theileriosis (Theileria lestoquardi): A review. Jordan J. Biol. Sci. 2015, 8, 165–174. [Google Scholar]
- Habela, M.; Reina, D.; Niecto, C.; Navarrete, I. Theileria ovis in Extremadura, Spain. Study of pathogenicity. Rev. Iber. Parasitol. 1989, 49, 117. [Google Scholar]
- Al-Fahdi, A.; Alqamashoui, B.; Al-Hamidhi, S.; Kose, O.; Tageldin, M.H.; Bobade, P.; Johnson, E.H.; Hussain, A.-R.; Karagenc, T.; Tait, A.; et al. Molecular surveillance of Theileria parasites of livestock in Oman. Ticks Tick-Borne Dis. 2017, 8, 741–748. [Google Scholar] [CrossRef]
- Gharbi, M.; Touay, A.; Khayeche, M.; Laarif, J.; Jedidi, M.; Sassi, L.; Darghouth, M. Ranking control options for tropical theileriosis in at-risk dairy cattle in Tunisia, using benefitcost analysis. Rev. Sci. Tech. l’OIE 2011, 30, 763–778. [Google Scholar] [CrossRef]
- Yaghfoori, S.; Mohri, M.; Razmi, G. Experimental Theileria lestoquardi infection in sheep: Biochemical and hematological changes. Acta Trop. 2017, 173, 55–61. [Google Scholar] [CrossRef]
- Elsadig, A.A.; Elmansoury, Y.H.A.; Babiker, A.A.A.; Abdelmageed, T.O.; Hussein, S. Effects of Theileria lestoquardi infection on haematological and biochemical parameters in experimentally infected desert ewes. Jordan J. Biol. Sci. 2013, 6, 316–319. [Google Scholar] [CrossRef][Green Version]
- Razmi, G.; Yaghfoori, S.; Mohri, M.; Haghparast, A.; Tajeri, S. The haematological, proinflammatory cytokines and IgG changes during an ovine experimental theileriosis. Onderstepoort J. Vet.-Res. 2019, 86, e1–e6. [Google Scholar] [CrossRef]
- Baghshani, H.; Razmi, G.R.; Yaghfouri, S.; Dezaki, A.A. Investigation of selected biochemical parameters in sheep naturally infected with theileriosis. Comp. Clin. Path 2012, 21, 1417–1420. [Google Scholar] [CrossRef]
- Yaghfoori, S.; Razmi, G.R.; Mohri, M.; Razavizadeh, A.R.T.; Movassaghi, A.R. An experimental ovine Theileriosis: The effect of Theileria lestoquardi infection on cardiovascular system in sheep. Acta Trop. 2016, 161, 55–61. [Google Scholar] [CrossRef] [PubMed]
- Altay, K.; Dumanli, N.; Holman, P.J.; Aktas, M. Detection of Theileria ovis infected sheep by nested PCR. Vet. Parasitol 2005, 127, 99–104. [Google Scholar] [CrossRef] [PubMed]
- Yin, H.; Liu, G.; Luo, J.; Guan, G.; Ma, M.; Ahmed, J.; Bai, Q. Observation on the schizont stage of an unidentified Theileria sp. in experimentally infected sheep. Parasitol. Res. 2003, 91, 34–39. [Google Scholar] [CrossRef]
- Gao, Y.; Yin, H.; Luo, J.; Ouyang, W.; Bao, H.; Guan, G.; Zhang, Q.; Lu, W.; Ma, M. Development of an enzyme-linked immunosorbent assay for the diagnosis of Theileria sp. infection in sheep. Parasitol. Res. 2002, 88, S8–S10. [Google Scholar] [CrossRef]
- Lu, Y.; Guan, G.; Jiang, T.; Li, Y.; Yang, J.; Liu, G.; Luo, J.; Yin, H.; Liu, Z. Development of an immunochromatographic strip for the serodiagnosis of Theileria infection in sheep. Parasites Vectors 2015, 8, 621. [Google Scholar] [CrossRef] [PubMed]
- Miranda, J.P.G.; Bakheit, M.A.; Liu, Z.; Yin, H.; Mu, Y.; Guo, S.; Beyer, D.; Oliva, A.; Ahmed, J.S.; Seitzer, U. Development of a recombinant indirect ELISA for the diagnosis of Theileria sp. (China) infection in small ruminants. Parasitol. Res. 2006, 98, 561–567. [Google Scholar] [CrossRef] [PubMed]
- Liu, Z.; Wang, Z.; Yin, H.; Luo, J.; Zhang, B.; Kullmann, B.; Abdo, J.; Salih, D.; Ahmed, J.; Seitzer, U. Identification of Theileria uilenbergi immunodominant protein for development of an indirect ELISA for diagnosis of ovine theileriosis. Int. J. Parasitol. 2010, 40, 591–598. [Google Scholar] [CrossRef] [PubMed]
- Liu, Z.; Li, Y.; Salih, D.E.A.; Luo, J.; Ahmed, J.S.; Seitzer, U.; Yin, H. Validation of a recombinant protein indirect ELISA for the detection of specific antibodies against Theileria uilenbergi and Theileria luwenshuni in small ruminants. Vet. Parasitol. 2014, 204, 139–145. [Google Scholar] [CrossRef]
- Hassan, S.; Skilton, R.; Pelle, R.; Odongo, D.; Bishop, R.; Ahmed, J.; Seitzer, U.; Bakheit, M.; El Hussein, A. Assessment of the prevalence of Theileria lestoquardi in sheep from the Sudan using serological and molecular methods. Prev. Vet.-Med. 2019, 169, 104697. [Google Scholar] [CrossRef] [PubMed]
- Lempereur, L.; Beck, R.; Fonseca, I.; Marques, C.; Duarte, A.; Santos, M.; Zúquete, S.; Gomes, J.; Walder, G.; Domingos, A.; et al. Guidelines for the Detection of Babesia and Theileria Parasites. Vector Borne Zoonotic Dis. 2017, 17, 51–65. [Google Scholar] [CrossRef] [PubMed]
- Zaeemi, M.; Haddadzadeh, H.; Khazraiinia, P.; Kazemi, B.; Bandehpour, M. Identification of different Theileria species (Theileria lestoquardi, Theileria ovis, and Theileria annulata) in naturally infected sheep using nested PCR–RFLP. Parasitol. Res. 2010, 108, 837–843. [Google Scholar] [CrossRef]
- Nangru, A.; Maharana, B.R.; Vohra, S.; Kumar, B. Molecular identification of Theileria species in naturally infected sheep using nested PCR-RFLP. Parasitol. Res. 2022, 121, 1487–1497. [Google Scholar] [CrossRef] [PubMed]
- Yin, H.; Liu, Z.; Guan, G.; Liu, A.; Ma, M.; Ren, Q.; Luo, J. Detection and Differentiation of Theileria luwenshuni and T. uilenbergi Infection in Small Ruminants by PCR. Transbound. Emerg. Dis. 2008, 55, 233–237. [Google Scholar] [CrossRef] [PubMed]
- Liu, Z.; Hou, J.; Bakheit, M.A.; Salih, D.A.; Luo, J.; Yin, H.; Ahmed, J.S.; Seitzer, U. Development of loop-mediated isothermal amplification (LAMP) assay for rapid diagnosis of ovine theileriosis in China. Parasitol. Res. 2008, 103, 1407–1412. [Google Scholar] [CrossRef] [PubMed]
- Salih, D.A.; Ali, A.M.; Liu, Z.; Bakheit, M.A.; Taha, K.M.; El Imam, A.H.; Kullmann, B.; El Hussein, A.M.; Ahmed, J.S.; Seitzer, U. Development of a loop-mediated isothermal amplification method for detection of Theileria lestoquardi. Parasitol. Res. 2012, 110, 533–538. [Google Scholar] [CrossRef] [PubMed]

| Species | Presence of Anaemia | Other Clinical Signs | Pathogenicity |
|---|---|---|---|
| B. ovis | Yes | Fever Haemoglobunuria Jaundice Wasting condition | ++++ |
| B. motasi | Yes | ||
| +++/++ | |||
| B. crassa | No | + |
| Species | Presence of Anaemia | Other Clinical Signs | Pathogenicity |
|---|---|---|---|
| T. lestoquardi | Yes | Fever Inappetence Weakness Anorexia Jaundice | ++++ |
| T. uilenbergi | Yes | +++/++ | |
| T. luwenshuni | Yes | +++/++ | |
| T. ovis | No | Subclinical infection | −/+ (immunocompromised animals) |
| T. separata | No | Subclinical infection | −/+ (immunocompromised animals) |
| T. recondita | No | Subclinical infection | −/+ (immunocompromised animals) |
Publisher’s Note: MDPI stays neutral with regard to jurisdictional claims in published maps and institutional affiliations. |
© 2022 by the authors. Licensee MDPI, Basel, Switzerland. This article is an open access article distributed under the terms and conditions of the Creative Commons Attribution (CC BY) license (https://creativecommons.org/licenses/by/4.0/).
Share and Cite
Villanueva-Saz, S.; Borobia, M.; Fernández, A.; Jiménez, C.; Yzuel, A.; Verde, M.T.; Ramo, M.Á.; Figueras, L.; Ruíz, H. Anaemia in Sheep Caused by Babesia and Theileria Haemoparasites. Animals 2022, 12, 3341. https://doi.org/10.3390/ani12233341
Villanueva-Saz S, Borobia M, Fernández A, Jiménez C, Yzuel A, Verde MT, Ramo MÁ, Figueras L, Ruíz H. Anaemia in Sheep Caused by Babesia and Theileria Haemoparasites. Animals. 2022; 12(23):3341. https://doi.org/10.3390/ani12233341
Chicago/Turabian StyleVillanueva-Saz, Sergio, Marta Borobia, Antonio Fernández, Calasanz Jiménez, Andrés Yzuel, María Teresa Verde, María Ángeles Ramo, Luis Figueras, and Héctor Ruíz. 2022. "Anaemia in Sheep Caused by Babesia and Theileria Haemoparasites" Animals 12, no. 23: 3341. https://doi.org/10.3390/ani12233341
APA StyleVillanueva-Saz, S., Borobia, M., Fernández, A., Jiménez, C., Yzuel, A., Verde, M. T., Ramo, M. Á., Figueras, L., & Ruíz, H. (2022). Anaemia in Sheep Caused by Babesia and Theileria Haemoparasites. Animals, 12(23), 3341. https://doi.org/10.3390/ani12233341

